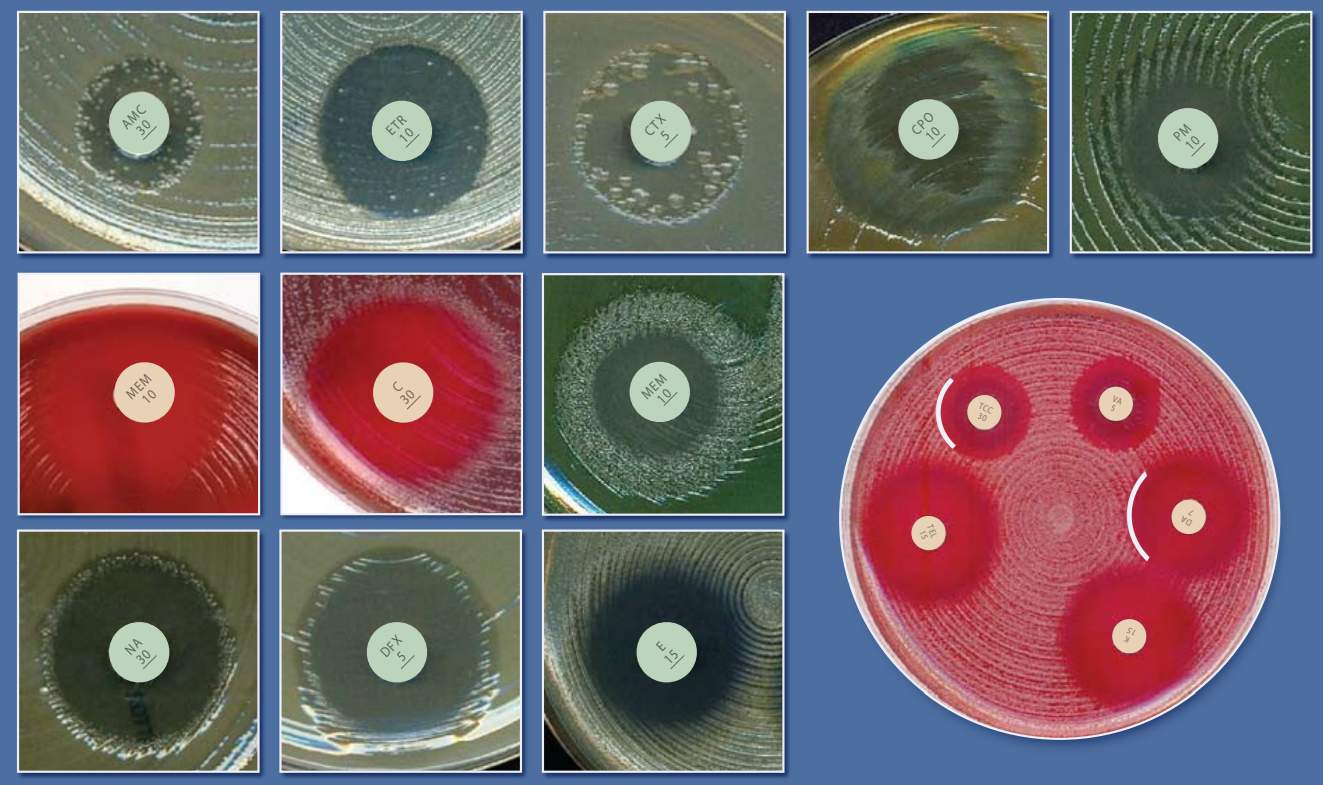
Российские рекомендации по определению чувствительности 2025

Опыт внедрения АБиоГрам в крупнейшую лабораторию города Москвы: апробация показала 150–200× ускорение проверки и выявления несоответствий в микробиологических заключениях
Итоги апробации в крупнейшей лаборатории города Москвы (07.11–25.11.2025): интеграция с ЛИС по API, автоматическая категоризация результатов определения чувствительности, 89 117 справочных сообщений и аналитика антимикробной резистентности в реальном времени